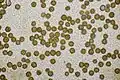
Sporen

Wortelende aardappelbovist
| Wortelende aardappelbovist | ||||||||||||||
|---|---|---|---|---|---|---|---|---|---|---|---|---|---|---|
| Taxonomische indeling | ||||||||||||||
| ||||||||||||||
| Soort | ||||||||||||||
| Scleroderma verrucosum (Bull.) Pers. (1801 [1]) | ||||||||||||||
| Afbeeldingen op | ||||||||||||||
| ||||||||||||||
De wortelende aardappelbovist (Scleroderma verrucosum) is een schimmel. De soort vormt ectomycorrhiza. De vruchtlichamen groeien op de grond van voedselrijke, humusrijke, kalkloze tot kalkarme zand-, leem- en kleibodems, vaak in loofbossen- of gemengde bossen, houtwallen, parken, struwelen, lanen en heiden.[2]
Kenmerken
Uiterlijke kenmerken
Het vruchtlichaam heeft vaak de vorm van een afgeplatte knol, waarbij de basis langwerpig is. Het heeft een leerachtige buitenhuid (peridia), die aanvankelijk glad is en later bedekt met talloze kleine bruine schubben op een lichte achtergrond. De kleur varieert tussen geel en bruin. Het vruchtvlees van jonge vruchtlichamen is wit en stevig; het heeft een onaangename geur en een zure smaak. Later wordt het vruchtvlees zacht en krijgt het een olijfbruine tint. Op volwassen leeftijd bestaat de binnenzijde uit zwart sporenpoeder. Het vruchtlichaam scheurt aan de bovenkant open zodat de rijpe sporen in de vorm van stofwolken ontsnappen.
KOH op het oppervlak kleurt roze, soms na een gele reactie.
Microscopische kenmerken
De sporen hebben een diameter van 8 tot 11,6 µm (exclusief stekels). De stekels zijn tussen de 1,0 en 1,4 µm lang.
Verspreiding
De wortelende aardappelbovist heeft een kosmopolitische verspreiding en groeit in de grond op voedselrijke zandgronden. De soort is gevonden in Afrika, Azië (China en India), Australië, Europa, Noord-Amerika (inclusief Hawaï) en Zuid-Amerika.
In Nederland komt hij zeer algemeen voor. Hij staat niet op de rode lijst en is niet bedreigd.[2]
Naamgeving
De soortnaam werd gepubliceerd in 1791 door Pierre Bulliard als Lycoperdon verrucosum. Christiaan Hendrik Persoon bracht de soort in 1801 over naar Scleroderma. De soortaanduiding verrucosum betekent "wrattig".
Eetbaarheid
De wortelende aardappelbovist is giftig. Consumptie kan leiden tot spijsverteringsproblemen zoals braken en buikpijn. Daarnaast kunnen zweten en lage bloeddruk met duizeligheid, mogelijk bewusteloosheid, optreden. Het giftige effect kan al 30 tot 45 minuten na de paddenstoelenmaaltijd optreden. Visuele stoornissen en abnormale waarneming zijn ook in individuele gevallen na consumptie opgetreden.
Het is niet bekend welke stoffen verantwoordelijk zijn voor het toxische effect.
Foto's
- Zijaanzicht
Sporen
Sporen